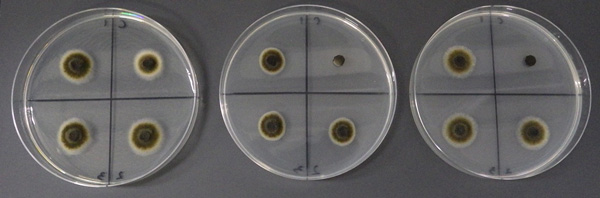
PDAのみ（左）、ペンチオピラド100ppm 添加（中央）、ピラジフルミド100ppm 添加（右） ※右上：感受性菌（対照）、左上・右下・左下：分離菌1～3（提供：北海道立総合研究機構）

【特殊報】ブロッコリーの黒すす病にSDHI剤耐性菌が発生 北海道2025年12月25日
北海道病害虫防除所は、ブロッコリーの黒すす病において、SDHI剤耐性菌が発生していることから、12月24日に令和7年度病害虫発生予察特殊報第1号を発表した。
PDAのみ(左)、ペンチオピラド100ppm 添加(中央)、ピラジフルミド100ppm 添加(右)
PDAのみ(左)、ペンチオピラド100ppm 添加(中央)、ピラジフルミド100ppm 添加(右)
※右上:感受性菌(対照)、左上・右下・左下:分離菌1~3(提供:北海道立総合研究機構)
北海道病害虫防除所によると近年、ブロッコリーにおいてSDHI剤を用いて防除を行っても黒すす病の発生が認められる事例が発生しており、2025年に道外で耐性菌の発生が確認された。また、道内でも一部地域で感受性の低下が報告されたことから、北海道立総合研究機構農業試験場において薬剤に対する感受性検定を実施したところ、SDHI剤に対する耐性菌の発生が広く確認された。
発生の確認経過
同所では8~10月、石狩、後志、檜山、胆振、上川、十勝及びオホーツク地方の栽培ほから同病り病葉またはり病花蕾を採取し、病斑部から菌株を得た。これらの菌株について、薬剤添加培地上での生育確認(培地検定)した結果、SDHI剤に対する耐性菌がすべての地方で高頻度に認められた(表1)。
 表1:ブロッコリー黒すす病菌のSDHI剤耐性菌検定結果
表1:ブロッコリー黒すす病菌のSDHI剤耐性菌検定結果
これらの菌株に対する実際の防除効果は未検討であるが、道外において耐性菌と推察される菌株が発生したほ場では、防除効果の低下が確認されている。
同所では次のとおり防除対策を呼びかけている。
(1) 同病を対象とした茎葉散布防除にはSDHI剤の使用を避ける。
(2) 同病に対する登録農薬はSDHI剤の他ではQoI剤があるが、耐性菌発生リスクが高いことから、QoI剤の使用は1作型に付き1回にとどめる。
(3) SDHI剤及びQoI剤以外の系統の薬剤(ポリオキシンD亜鉛塩水和剤、オキソリニック酸・有機銅水和剤、銅水和剤)の使用を検討する。
(4) 隣接して栽培している作型への感染リスクが高いため、収穫後は速やかに残渣をすき込む。
重要な記事
最新の記事
-
 【注意報】ムギ類赤かび病 県内全域で多発のおそれ 三重県2026年4月6日
【注意報】ムギ類赤かび病 県内全域で多発のおそれ 三重県2026年4月6日 -
 【浜矩子が斬る! 日本経済】日本国債の金縁がメッキと化す時2026年4月6日
【浜矩子が斬る! 日本経済】日本国債の金縁がメッキと化す時2026年4月6日 -
 道の駅「すばしり」でトラブル 指定管理期間満了後も前管理者が「営業」継続 小山町、明け渡し迫る2026年4月6日
道の駅「すばしり」でトラブル 指定管理期間満了後も前管理者が「営業」継続 小山町、明け渡し迫る2026年4月6日 -
 【JA人事】JA西印旛 新組合長に板橋章氏(3月28日)2026年4月6日
【JA人事】JA西印旛 新組合長に板橋章氏(3月28日)2026年4月6日 -
 米価水準「低くなる」見方続く 3月の関係者調査結果2026年4月6日
米価水準「低くなる」見方続く 3月の関係者調査結果2026年4月6日 -
 【役員人事】三菱マヒンドラ農機(4月30日付)2026年4月6日
【役員人事】三菱マヒンドラ農機(4月30日付)2026年4月6日 -
 悩んだときは「原点」へ 食と農振興のうねり、ここから 西井賢悟・JCA主席研究員が講演2026年4月6日
悩んだときは「原点」へ 食と農振興のうねり、ここから 西井賢悟・JCA主席研究員が講演2026年4月6日 -
 ベトナム進出を検討中の食品関連企業 現地官民ミッション参加者を募集 農水省2026年4月6日
ベトナム進出を検討中の食品関連企業 現地官民ミッション参加者を募集 農水省2026年4月6日 -
 小学生以下の卓球大会スタート 未来のスター候補を「ニッポンの食」で応援 JA全農2026年4月6日
小学生以下の卓球大会スタート 未来のスター候補を「ニッポンの食」で応援 JA全農2026年4月6日 -
 JAタウン「ぎふ~JAめぐみのマルシェ~」母の日早期割引キャンペーン開催中2026年4月6日
JAタウン「ぎふ~JAめぐみのマルシェ~」母の日早期割引キャンペーン開催中2026年4月6日 -
 お得な出荷価格で販売「第55回東京都農業祭~植木部門~」開催 JA東京中央会2026年4月6日
お得な出荷価格で販売「第55回東京都農業祭~植木部門~」開催 JA東京中央会2026年4月6日 -
 米価暴落のXデーは来るか【森島 賢・正義派の農政論】2026年4月6日
米価暴落のXデーは来るか【森島 賢・正義派の農政論】2026年4月6日 -
 GREEN×EXPO 2027の新規協賛募集 出展、コンペ、ジェンダー、賓客接遇で2026年4月6日
GREEN×EXPO 2027の新規協賛募集 出展、コンペ、ジェンダー、賓客接遇で2026年4月6日 -
 復興のその先を届ける「熊本地震10年復興マルシェ」開催 ビビッドガーデン2026年4月6日
復興のその先を届ける「熊本地震10年復興マルシェ」開催 ビビッドガーデン2026年4月6日 -
 繁殖牛・肥育牛管理システム「USHIX(ウシックス)」に完全リニューアル 南日本情報処理センター2026年4月6日
繁殖牛・肥育牛管理システム「USHIX(ウシックス)」に完全リニューアル 南日本情報処理センター2026年4月6日 -
 食文化創造都市推進プロジェクト支援 新たなチャレンジを募集 新潟市2026年4月6日
食文化創造都市推進プロジェクト支援 新たなチャレンジを募集 新潟市2026年4月6日 -
 最新法令対応の農業会計ソフト「農業簿記13」22日に発売 ソリマチ2026年4月6日
最新法令対応の農業会計ソフト「農業簿記13」22日に発売 ソリマチ2026年4月6日 -
 再生農業で環境負荷を低減した麦芽「リジェノヴァ」ビールに初めて採用 サッポロビール2026年4月6日
再生農業で環境負荷を低減した麦芽「リジェノヴァ」ビールに初めて採用 サッポロビール2026年4月6日 -
 カルビー「食育実践優良法人2026」に認定2026年4月6日
カルビー「食育実践優良法人2026」に認定2026年4月6日 -
 「日本気候リーダーズ・パートナーシップ(JCLP)」へ加盟 ヤマタネ2026年4月6日
「日本気候リーダーズ・パートナーシップ(JCLP)」へ加盟 ヤマタネ2026年4月6日




































































